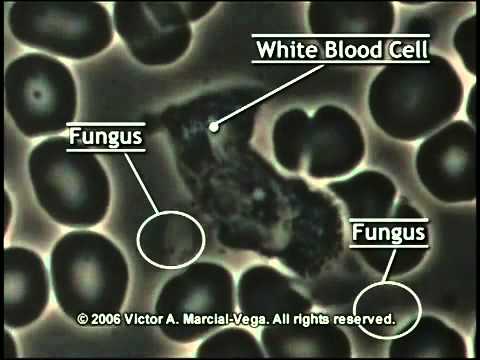

Goji Marjad }}- Goji marjad osta siit: ...
Before downloading Download Goji Marjad Mp3 dan Mp4 Youtube Gratis Mp3 Mp4 3gp , you can preview any Video by mouse over the PLAY VIDEO button and click Play or Click DOWNLOAD button to download hd quality Mp3, Mp4 and 3Gp files.
Goji Marjad MP3 dan MP4 Youtube :
Download Free Mp3 Video Mp4 Veri Enne Ja Pärast Goji Marjade Söömist | Download Goji Marjad Mp3 dan Mp4 Youtube
Download Free Mp3 Video Mp4 Kaerahelbe Toorpuder, Toortatra Puder Ja Chia Seemne Puding | Download Goji Marjad Mp3 dan Mp4 Youtube
Download Free Mp3 Video Mp4 Goji Berries (Lycium Chinense) | Download Goji Marjad Mp3 dan Mp4 Youtube
Download Free Mp3 Video Mp4 Choco Lite Naturaalne Salenemis Preparaat [ Estonian ] | Download Goji Marjad Mp3 dan Mp4 Youtube
Download Free Mp3 Video Mp4 Toidukuivati Ehk Dehüdraator Saates ETV Ringvaade | Download Goji Marjad Mp3 dan Mp4 Youtube
That is the search result about Download Goji Marjad Mp3 Mp4 Youtube if you want to search for others songs, mp3s, video clips,, please search at search column above. [Download Toidukuivati ehk dehüdraator saates ETV Ringvaade, Mp3 Download Goji Marjad Mp3 Mp4 Youtube Lyrics & Videoklip]
Posting Komentar
Posting Komentar